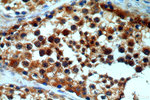
ASUN Antibody in Immunohistochemistry (Paraffin) (IHC (P))

Search
Proteintech
ASUN Polyclonal Antibody
{{$productOrderCtrl.translations['antibody.pdp.commerceCard.promotion.promotions']}}
{{$productOrderCtrl.translations['antibody.pdp.commerceCard.promotion.viewpromo']}}
{{$productOrderCtrl.translations['antibody.pdp.commerceCard.promotion.promocode']}}: {{promo.promoCode}} {{promo.promoTitle}} {{promo.promoDescription}}. {{$productOrderCtrl.translations['antibody.pdp.commerceCard.promotion.learnmore']}}
产品信息
19892-1-AP
种属反应
已发表种属
宿主/亚型
分类
类型
抗原
偶联物
形式
浓度
规格
纯化类型
保存液
内含物
保存条件
运输条件
产品详细信息
Immunogen sequence: GRSVLLEQP RKSGSKVISH MLSSHGGEIF LHVLSSSRSI LEDPPSISEG CGGRVTDYRI TDFGEFMREN RLTPFLDPRY KIDGSLEVPL ERAKDQLEKH TRYWPMIISQ TTIFNMQAVV PLASVIVKES LTEEDVLNCQ KTIYNLVDME RKNDPLPIST VGTRGKGPKR DEQYRIMWNE LETLVRAHIN NSEKHQRVLE CLMACRSKPP EEEERKKRGR KREDKEDKSE KAVKDYEQEK SWQDSERLKG ILERGKEELA EAEIIKDSPD SPEPPNKKPL VEMDETPQVE KSKGPVSLLS LWSNRINTAN SRKHQEFAGR LNSVNNRAEL YQHLKEENGM ETTKNGKASR Q (357-706 aa encoded by BC003081)
靶标信息
Crucial regulator of the mitotic cell cycle and development. At prophase, required for dynein anchoring to the nuclear envelope important for proper centrosome-nucleus coupling. At G2/M phase, may be required for proper spindle formation and execution of cytokinesis. Probable component of the Integrator (INT) complex, a complex involved in the small nuclear RNAs (snRNA) U1 and U2 transcription and in their 3'-box-dependent processing (PubMed:23904267). [UniProt]
仅用于科研。不用于诊断过程。未经明确授权不得转售。
生物信息学
蛋白别名: asunder, spermatogenesis regulator homolog (Drosphila); Cell cycle regulator Mat89Bb homolog; Germ cell tumor 1; Integrator complex subunit 13; NB4 apoptosis related protein; Protein asunder homolog; Sarcoma antigen NY-SAR-95; spermatogenesis associated 30; unnamed protein product
基因别名: ASUN; C12orf11; GCT1; INTS13; Mat89Bb; NET48; SPATA30
UniProt ID: (Human) Q9NVM9
Entrez Gene ID: (Human) 55726